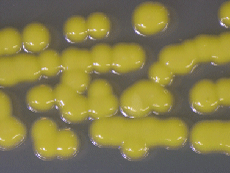

◆◇◆ ━━━━━━━━━━━━━━━━━━━━━━━━━━━ ◆◇◆
NBRCニュース No. 27(2014.6.2)
◆◇◆ ━━━━━━━━━━━━━━━━━━━━━━━━━━━ ◆◇◆
NBRCニュース第27号をお届けします。今号は微生物あれこれ、微生物の保存
法、NITEが解析した微生物ゲノムの3つの連載をお届けします。微生物ではあ
りませんが、今回の保存法では、動物細胞の凍結保存法を紹介いたします。最
後までお読みいただければ幸いです。
(等幅フォントでご覧ください)
======================================================================
内容
======================================================================
1.新たにご利用可能となった微生物株(2014年3月18日~5月19日)
2.微生物あれこれ(24)
ミクロコッカス・ルテウスはコクリア・リゾフィラに変わった?
3.微生物の保存法(14)
動物細胞の凍結保存法
4.NITEが解析した微生物ゲノム(13)
Multilocus sequence analysis(MLSA)について
5.微生物の産業利用に向けた安全性情報の提供について
====================================================================== 1.新たにご利用可能となった微生物株(2014年3月18日~5月19日) ====================================================================== 酵母 2株、糸状菌 9株、細菌 33株、アーキア 1株、藻類 15株を新たに公開 しました。 【新規公開株一覧】 https://www.nite.go.jp/nbrc/cultures/nbrc/new_strain/new_dna.html
====================================================================== 2.微生物あれこれ(24) ミクロコッカス・ルテウスはコクリア・リゾフィラに変わった? (浜田盛之) ====================================================================== ミクロコッカス・ルテウス(Micrococcus luteus)という種をご存じでしょ うか?この種は抗生物質生産で有名な放線菌の仲間ですが、細胞形態は典型的 な球菌で、一般的な放線菌のように菌糸状にはならず、抗生物質も生産しませ ん。各種抗生物質に対する感受性が高いことから、抗生物質の検定菌として広 く用いられており、日本薬局方に規定される抗生物質の微生物学的力価試験や 食品衛生法に基づく食品中の残留抗生物質試験等の公定試験に指定されている 株があります。このミクロコッカス・ルテウスを古くからご利用いただいてい るユーザーの皆様から、「ミクロコッカス・ルテウスの種名がコクリア・リゾ フィラ(Kocuria rhizophila)に変わっているが何故?」とお問い合わせをい ただくことがあります。そこで今回は、この2つの名前の関係について説明い たします。 古くから世界中で検定菌として利用されているNBRC 12708(= ATCC 9341) は、最初にサルシナ・ルテア(Sarcina lutea)に同定され、1977年以降はミ クロコッカス・ルテウスとして取り扱われていました。しかし、DNA塩基配列 解析技術を代表とする分析技術の進歩に伴い、アメリカの研究グループがこの 株の詳細な分類学的研究を行い、2003年にコクリア・リゾフィラに再同定した 論文を発表しました。第十六改正日本薬局方(平成23年)においては「Micro- coccus luteus ATCC 9341」と記載されたままですが、NBRCでは当該菌株の名称 をこの論文に従って、正しい学名である「Kocuria rhizophila」に変更してお ります。表記している学名が異なっていても同じ株であり、試験結果も有効で すので、従来通りNBRC 12708株をご利用ください。一方で、再同定に関するこ の発表は、NBRC 12708(= ATCC 9341)株に対する名称変更であり、ミクロコ ッカス・ルテウスという種そのものがコクリア・リゾフィラに変わった訳では ないので注意が必要です。従って、ミクロコッカス・ルテウスに属する株を用 いた試験を行いたい場合や、試験法に株番号の指定が無く、ミクロコッカス・ ルテウスを使用するようにとだけ記載されている場合は、分類学的基準株であ るMicrococcus luteus NBRC 3333をご利用いただくことをお勧めいたします。 このように、本件は最も広く利用されていた有名な株が別の種に再同定され たため、混乱を引き起こしたケースと言えます。しかし、株レベルの同定の問 題のみならず、微生物分類学の世界では属や種といった分類群そのものの再分 類が絶えず行われています。NBRCでは最新の分類に基づいて保有株の学名を随 時変更しておりますので、過去にご利用いただいた時と菌株の学名が変わって いることがあるかもしれません。菌株の名前についてご不明な点があれば、お 気軽にお問い合わせください。
Kocuria rhizophila NBRC 12708のコロニー画像
なお、2010年以降のNBRC株の学名変更については、以下のウェブページで公 開しておりますので、ご参考ください。 【菌株名変更履歴】 https://www.nite.go.jp/nbrc/cultures/nbrc/change/modification.html
====================================================================== 3.微生物の保存法(14) 動物細胞の凍結保存法 (佐藤真則) ====================================================================== 動物細胞はこれまでご紹介してきました各種微生物のように凍結による保存 が可能です。ただ微生物の多くは超低温槽(-80℃)で保存できますが、動物 細胞の場合、その温度では1年以内に生存率が低下するため必ず液体窒素タン ク気相(-170℃)で保存します。一般的な癌細胞や培養という環境に適応し た細胞株は、この条件で半永久的に保存が可能だと言われています。ただし、 生体から取り出したばかりの初代培養細胞や幹細胞などの中には凍結に弱いも のもありますし、生体そのものや臓器などの組織レベルでの凍結保存は現在の ところ不可能です。今回は凍結が可能な一般的な動物細胞の保存法についてご 紹介します。 ◆動物細胞の準備 細胞は対数増殖期後期のものを準備し、凍結処理前日に培地交換を行ってお きます。接着性細胞の場合、細胞が培養器に張り付いた状態のまま、培地をア スピレーターで吸引して除き、そこへ細胞がはがれないように新鮮な培地を静 かに入れます。浮遊性の場合は、200×gで3-5分、遠心分離して上清を捨てた 後に新しい培地を入れるか、遠心せず培養液の半分を捨て、捨てた容量分の新 しい培地を入れます。可能ならば形態の正常性、細胞固有の特徴の保持、汚染 の有無(マイコプラズマなどの微生物の混入や他の動物細胞の混入や置き換わ り)について確認するとよいでしょう。普段抗生物質を添加して培養を行って いる場合には抗生物質を添加せずに2、3回継代培養してから各種汚染検査を行 っておきます。 ◆動物細胞の凍結 (1) 培養用培地にDMSOを最終濃度が10%(v/v)になるように添加した保存用培 地を準備します。DMSOを培地に混ぜると発熱するので必ず前もって混ぜて おきます。保存用培地の代わりにセルバンカー等の市販品を使用してもか まいません。 (2) 接着性細胞はトリプシン処理により細胞を剥離します。培養容器から培地 を除去し、0.02%EDTA-PBS溶液で2回以上洗浄します。次に0.25%トリプシ ン-0.02%EDTA-PBS溶液を加え37℃で静置します。倒立顕微鏡で大部分の細 胞がはがれたことが確認できたら培養用培地を加え、静かにピペッティン グをして細胞を完全に剥がします。200×gで3-5分遠心分離して細胞を集 め、上清を除去します。培地を除いて上記溶液で洗浄を行う理由は、血清 成分の一つであるトリプシンインヒビターを取り除くためと、細胞の接着 に必要な二価陽イオン(Ca, Mg)を除去するためです。浮遊性細胞は細胞 を含む培養液を同条件で遠心分離して、細胞を集めます。 (3) ペレット化した細胞を10e6~10e7 cells/mLの濃度で保存用培地に浮遊さ せます。 (4) (3)の細胞懸濁液を1 mLずつ、2 mL容の凍結保存用のプラスチックチュー ブに分注します。 (5) プログラムフリーザーもしくは1℃/分を目安に緩慢凍結が行えるフリージ ングコンテナ(BICELLやMr. Frosty等)を使用して-80℃まで予備凍結を 行います。-80℃で少なくとも4-6時間静置します。 (6) (5)で予備凍結したチューブを取り出して液体窒素タンク気相に移し、保 管します。

接着性細胞のトリプシン処理による細胞剥離の様子
◆凍結保存した動物細胞の復元培養 細胞の増殖を抑制するDMSOを取り除いてから、培養します。 (1) 培養用の培地を10 mL入れた15 mL容の遠心チューブを用意します。 (2) 液体窒素タンクから動物細胞を凍結保存していたチューブを取り出し、37 ℃の湯浴で融解します。手でゆらしながら、氷が少し残っている完全に融 けきる前の状態で湯浴から取り出します。 (3) チューブの表面を70%エタノール綿で拭いて消毒します。完全に融けたら 直ちにチューブのフタを開け、融解した細胞懸濁液1 mLをピペットで優し く吸い取り、(1)の遠心チューブの培地に添加して穏やかに混和します。 融解したばかりの細胞はとても弱いのでピペッティングや混和はできるだ け丁寧に行います。 (4) 200×gで3-5分で遠心分離し、上清を捨てます。 (5) 遠心分離で集めた細胞を1 mLの培地に懸濁し、生存率と生細胞数をトリパ ンブルー排除法で確認します。死んだ細胞の細胞膜は選択的透過性を失っ ており、トリパンブルーが透過するため、死細胞が染色されます。0.4%ト リパンブルー液と細胞が入った培地を1:1で混合し顕微鏡で観察すると、 全細胞数と染色された細胞の比率から生存率を求める事ができます。 (6) 細胞懸濁液を希釈してシャーレもしくはフラスコで培養を行います。 (7) 培養して24時間後に細胞形態やコンタミ、増殖能について確認します。

トリパンブルー排除法
最後に、一連の作業を行う際には必ずグローブと白衣を着用し、液体窒素タ ンクへのサンプルの出し入れや細胞の融解時には少なくとも眼鏡を、可能なら ばフェイスガードをした上で作業を行い、くれぐれも万が一の事故がありませ んようご注意いただければと思います。
====================================================================== 4.NITEが解析した微生物ゲノム(13) Multilocus sequence analysis(MLSA)について (下平 潤) ====================================================================== 微生物の属や種の同定は、研究開発、医療分野における臨床検査、食品製造 での品質管理等の様々な局面において、有用性や安全性の判断に必要です。細 菌の分類や同定では一般的に16S rRNA遺伝子の塩基配列が利用されています。 16S rRNA遺伝子の塩基配列は、ほぼすべての既知基準株についてデータベース 化されており、対象菌株から取得した配列をデータベースと比較することで容 易に同定することが可能となっています。しかし、近年では別種間でも配列が 完全に一致するケースが散見されるなど、16S rRNA遺伝子だけでは同定できな い例が増えています。そこで、国際原核生物分類命名委員会(International Committee on Systematics of Prokaryotes, ICSP)は、16S rRNA遺伝子に加 え、ハウスキーピング遺伝子(細胞の生育に必須であるため、全細胞で共通に 保存されていると考えられる遺伝子)を用いたMultilocus sequence analysis (MLSA)による菌種の同定を推奨しています(Stackebrandt et al. 2002)。 MLSAは複数のハウスキーピング遺伝子(5種類以上を推奨)の塩基配列または アミノ酸配列を連結して解析する方法であり、16S rRNA遺伝子のみによる系統 解析と比べ、高精度な解析を行うことができます。 MLSAは以下の手順で行います。 1.目的菌株及び近縁と考えられる基準株に共通して存在するハウスキーピ ング遺伝子の塩基配列またはアミノ酸配列をそれぞれ取得する。 2.菌株ごとに取得した配列を連結する。必要があれば各配列の長さを切り そろえた後に結合する。 3.作成した配列のMultiple alignmentを行い、系統樹を作成する。 使用するハウスキーピング遺伝子は、解析する菌株に共通して存在し、かつ 目的に適した相違度を示す必要があるため、分類群によって用いられる遺伝子 の組み合わせが異なります。そこで、NBRCでは、環境汚染物質分解菌としての 報告が多くありながら、日和見感染菌としての単離例も多く、16S rRNA遺伝子 の塩基配列を用いた系統解析法では識別が困難な分類群であるAcinetobacter 属およびComamonas属について、全ゲノム解析を行って適切な遺伝子の組み合 わせを見いだしました。Acinetobacter属では9遺伝子(cpn60、gltA、gyrB、 rplB、rpoD、fusA、gpi、pyrG、rpoB)、Comamonas属では7遺伝子(dnaA、 grpE、hemA、rpoB、dnaJ、gyrB、holB)の塩基配列を用いてMLSAを行なった結 果、16S rRNA遺伝子の塩基配列で描いた系統樹に比べて信頼性を示すブートス トラップ値が飛躍的に向上しました。また、16S rRNA遺伝子配列が100%一致し ているComamonas testosteroniとComamonas thiooxidansを明確に区別するこ とができました。詳細はMLSAの解説と併せてウェブページで公開しております ので、ご覧ください。 【MLSAの解説】 http://www.bio.nite.go.jp/safety/risk_assessment.html 【Acinetobacter属およびComamonas属のMLSA結果】 http://www.bio.nite.go.jp/safety/mlsa.html 【文献】 Stackebrandt et al. Int. J. Syst. Evol. Microbiol. 52: 1043- 1047 (2002).
====================================================================== 5.微生物の産業利用に向けた安全性情報の提供について (黄地祥子) ====================================================================== この度、これまで散在していた細菌の病原性や分類に関する文献情報や法規 制情報等について、整理・集約し公開しました。産業利用を行う際の微生物の リスク評価にご利用いただければ幸いです。 【詳細】 https://www.nite.go.jp/nbrc/information/release/140331.html 【微生物有害情報リスト】 https://www.nite.go.jp/nbrc/mrinda/list/ ====================================================================== 編集後記 ====================================================================== 花粉症の私にとって春はつらい季節です。ようやく花粉のピークが過ぎて、 快適な日々が過ごせるようになってきたと思っていたら、もう梅雨の足音が聞 こえてきました。しかし、今月はワールドカップがあります。寝不足が心配で すが、うっとうしい梅雨を楽しく過ごせそうです。がんばれ、日本。(YN) ◆◇◆ ━━━━━━━━━━━━━━━━━━━━━━━━━━━ ◆◇◆ ・受信アドレス変更、受信停止は以下のサイトからお手続きください。 https://www.nite.go.jp/nbrc/cultures/others/nbrcnews/nbrcnews.html ・NBRCニュースは配信登録いただいたメールアドレスにお送りしております。 万が一間違えて配信されておりましたら、お手数ですが、下記のアドレスに ご連絡ください。 ・ご質問、転載のご要望など、NBRCニュースについてのお問い合わせは、下記 のアドレスにご連絡ください。 ・掲載内容は予告なく変更することがございます。掲載内容を許可なく複製・ 転載されることを禁止します。 ・偶数月の1日(休日の場合はその前後)に配信します。第28号は8月1日に配 信予定です。 編集・発行 独立行政法人製品評価技術基盤機構(NITE)バイオテクノロジーセンター NBRCニュース編集局(nbrcnews@nite.go.jp) ◆◇◆ ━━━━━━━━━━━━━━━━━━━━━━━━━━━ ◆◇◆








